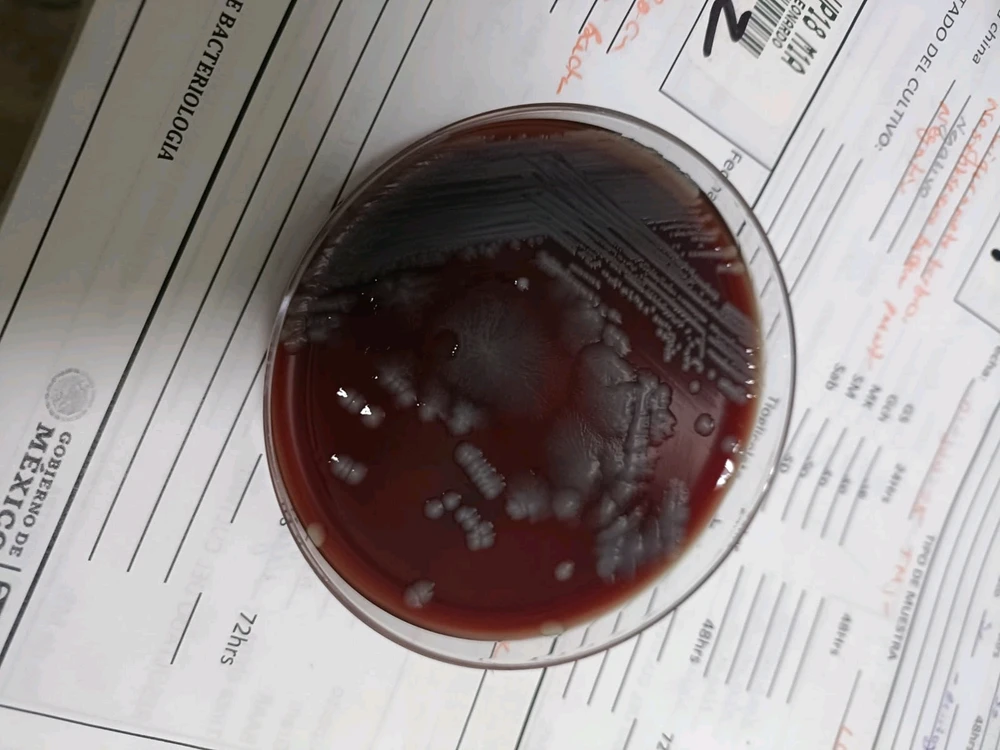
GIF subido por Javier

Bacteria Comunidad
La comunidad de bacteria, chatea, y debate.
14 almas
14 almas
¡Aún no hay publicaciones!
Conoce a Nuevas Personas
50.000.000+ DESCARGAS
2,4 M almas
13 mil almas
14 almas
13 mil almas
4,5 mil almas
3,6 mil almas
2,7 mil almas
2,2 mil almas
1 mil almas
953 almas
929 almas
791 almas
746 almas
724 almas
686 almas
644 almas
620 almas
552 almas
510 almas
504 almas
500 almas
455 almas
422 almas
398 almas
394 almas
356 almas
319 almas
317 almas
295 almas
260 almas
247 almas
228 almas
214 almas
201 almas
187 almas
186 almas
172 almas
129 almas
126 almas
124 almas
120 almas
101 almas
96 almas
94 almas
80 almas
78 almas
71 almas
62 almas
61 almas
56 almas
56 almas
54 almas
54 almas
52 almas
51 almas
48 almas
44 almas
43 almas
42 almas
38 almas
38 almas
34 almas
33 almas
31 almas
31 almas
31 almas
30 almas
29 almas
28 almas
26 almas
25 almas
23 almas
23 almas
23 almas
23 almas
21 almas
19 almas
17 almas
17 almas
16 almas
16 almas
16 almas
16 almas
15 almas
14 almas
14 almas
14 almas
13 almas
13 almas
12 almas
12 almas
11 almas
10 almas
10 almas
9 almas
9 almas
9 almas
8 almas
8 almas
8 almas
8 almas
8 almas
7 almas
7 almas
7 almas
6 almas
6 almas
5 almas
5 almas
5 almas
5 almas
5 almas
5 almas
5 almas
4 almas
4 almas
4 almas
4 almas
4 almas
3 almas
3 almas
3 almas
3 almas
3 almas
3 almas
3 almas
2 almas
2 almas
2 almas
2 almas
1 almas
1 almas
1 almas
1 almas
0 almas
La comunidad de bacteria, chatea, y debate.
14 almas
14 almas
¡Aún no hay publicaciones!
Conoce a Nuevas Personas
50.000.000+ DESCARGAS
Publicaciones Relacionadas
7m
ENFP
Sagitario
La Peste Negra fue una pandemia devastadora que asoló Europa, Asia y el norte de África en el siglo XIV (entre 1347 y 1351). Causada por la bacteria Yersinia pestis, transmitida principalmente por pulgas de ratas infectadas, provocó la muerte de aproximadamente un tercio de la población... leer más

24
6
12m
ISTP
Sagitario
Crecimiento de una bacteria de liquido cefalorraquideo
7
4
10m
INTJ
Virgo
Yo antes no creia en lo del niño interior o traumas infantiles, hasta que lo vi en mi mejor amigo :( Es difícil hablar de esto y más con quien tu quieres (con tal de no preocuparlo), pero ya con esto me doy cuenta el porque aveces no funcionan las relaciones (como de amistad o noviazgo) si... (editado) leer más

6
6
1m
INFJ
Acuario
Necesito hacer un juego de la oca pero no sé como exactamente tengo la idea alguien que ayude con el diseño como tal es sobre la bacteria lactobacillus casei

3
1
2m
INFP
Acuario
22
8
8m
ISFJ
Pseudomonads tagged with sGFP2 and mOrange fluorescent proteins

2
2